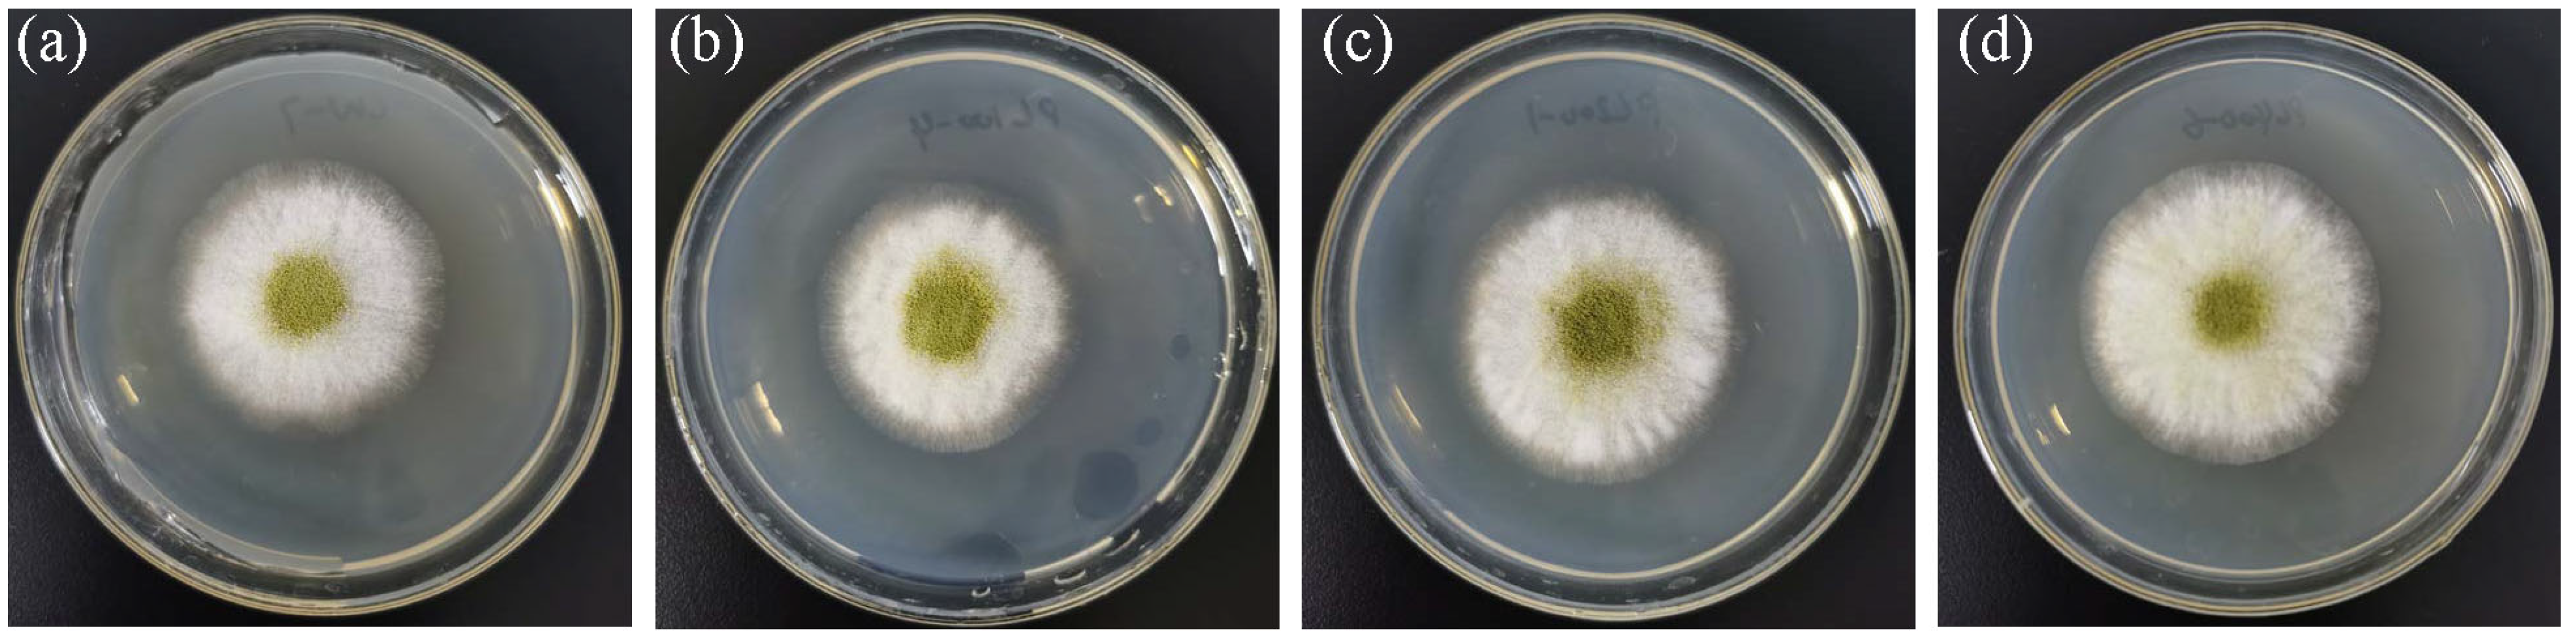
Fermentation 09 00674 g002 Fermentation 09 00674 g002

Effects of Pulsed Light on Mycelium Growth and Conidiation in Aspergillus oryzae
Abstract
1. Introduction
2. Materials and Methods
2.1. Fungal Species
2.2. Culture Conditions
2.3. Light Conditions and Apparatus
2.4. The Determination of Colony Diameter
2.5. The Measurement of Conidiation
2.6. Statistical Analyses
3. Results
3.1. The Appearance of Mycelium under PL
3.2. Mycelial Growth Responded to Pulsed Blue Light
3.3. Conidia Formation Responded to Pulsed Blue Light
3.4. Threshold Was Applicable to Pulsed Light
4. Discussion
5. Conclusions
Author Contributions
Funding
Institutional Review Board Statement
Data Availability Statement
Conflicts of Interest
References
- Fang, B.H.; Sun, J.A.; Dong, P.; Xue, C.H.; Mao, X.Z. Conversion of turbot skin wastes into valuable functional substances with an eco-friendly fermentation technology. J. Clean. Prod. 2017, 156, 367–377. [Google Scholar] [CrossRef]
- Hu, W.K.; Liu, Z.P.; Fu, B.; Zhang, X.L.; Qi, Y.G.; Hu, Y.; Wang, C.; Li, D.S.; Xu, N. Metabolites of the Soy Sauce Koji Making with Aspergillus niger and Aspergillus oryzae. Int. J. Food Sci. Technol. 2022, 57, 301–309. [Google Scholar] [CrossRef]
- Kovilein, A.; Aschmann, V.; Hohmann, S.; Ochsenreither, K. Immobilization of Aspergillus oryzae DSM 1863 for l-Malic Acid Production. Fermentation 2022, 8, 26. [Google Scholar] [CrossRef]
- Suzuki, S.; Ohmori, H.; Hayashida, S.; Nomura, M.; Kobayashi, M.; Hagi, T.; Narita, T.; Tomita, S.; Yamashita, H.; Arakawa, Y.; et al. Lipase and protease activities in Koji cheeses surface-ripened with Aspergillus strains. Food Sci. Technol. Res. 2021, 27, 543–549. [Google Scholar] [CrossRef]
- Mahboubi, A.; Ferreira, J.A.; Taherzadeh, M.J.; Lennartsson, P.R. Production of Fungal Biomass for Feed, Fatty Acids, and Glycerol by Aspergillus oryzae from Fat-Rich Dairy Substrates. Fermentation 2017, 3, 48. [Google Scholar] [CrossRef]
- Costa, S.; Summa, D.; Zappaterra, F.; Blo, R.; Tamburini, E. Aspergillus oryzae Grown on Rice Hulls Used as an Additive for Pretreatment of Starch-Containing Wastewater from the Pulp and Paper Industry. Fermentation 2021, 7, 317. [Google Scholar] [CrossRef]
- Ojima, Y.; Kusuda, A.; Nishioka, M.; Taya, M. Responses of Aspergillus oryzae to Stimuli from Near-UV Light Irradiation in the Presence or Absence of Titanium Dioxide. Biocontrol Sci. 2009, 14, 61–64. [Google Scholar] [CrossRef]
- Suzuki, S.; Kusumoto, K. Transcriptome Analysis of Two Strains of Aspergillus oryzae with Different Responses to Light. Jpn. Agric. Res. Q. JARQ 2020, 54, 13–20. [Google Scholar] [CrossRef]
- Zhao, S.; Niu, C.T.; Suo, J.Y.; Zan, Y.L.; Wei, Y.H.; Zheng, F.Y.; Liu, C.F.; Wang, J.J.; Li, Q. Unraveling the mystery of ‘bask in daytime and dewed at night’ technique in doubanjiang (broad bean paste) fermentation. LWT—Food Sci. Technol. 2021, 149, 111723. [Google Scholar] [CrossRef]
- Zhao, S.; Niu, C.T.; Wang, Y.H.; Li, X.Y.; Zheng, F.Y.; Liu, C.F.; Wang, J.J.; Li, Q. Revealing the contributions of sunlight-expose process and core-microbiota metabolism on improving the flavor profile during Doubanjiang fermentation. Food Biosci. 2023, 53, 102522. [Google Scholar] [CrossRef]
- Lin, S.; Qin, H.; Zhang, X.; Li, W.; Liu, M. Inhibition of Aspergillus oryzae Mycelium Growth and Conidium Production by Irradiation with Light at Different Wavelengths and Intensities. Microbiol. Spectr. 2021, 9, e00213-21. [Google Scholar] [CrossRef] [PubMed]
- Murthy, P.S.; Sano, M.; Hattori, R.; Kusumoto, K.; Suzuki, S. Aspergillus oryzae Strain with Improved Conidiation after Light Stimulation. Jpn. Agric. Res. Q. JARQ 2018, 52, 23–28. [Google Scholar] [CrossRef]
- Hatakeyama, R.; Nakahama, T.; Higuchi, Y.; Kitamoto, K. Light represses conidiation in koji mold Aspergillus oryzae. Biosci. Biotechnol. Biochem. 2007, 71, 1844–1849. [Google Scholar] [CrossRef] [PubMed]
- Murthy, P.S.; Suzuki, S.; Kusumoto, K.I. Effect of Light on the Growth and Acid Protease Production of Aspergillus oryzae. Food Sci. Technol. Res. 2015, 21, 631–635. [Google Scholar] [CrossRef]
- Dong, Y.T.; Ma, H.L.; Zhou, C.S.; Golly, M.K.; Wu, P.; Sun, L.; Yagoub, A.A.; He, R.H.; Ye, X.F. Enhanced Mycelium Production of Phellinus igniarius (Agaricomycetes) Using a He-Ne Laser with Pulsed Light. Int. J. Med. Mushrooms 2021, 23, 59–69. [Google Scholar] [CrossRef]
- Rasiukeviciute, N.; Brazaityte, A.; Valiuskaite, A.; Vastakaite-Kairiene, V. The inhibition of Colletotrichum acutatum by monochromic pulsed and non-pulsed radiation at different time durations. ISHS Acta Hortic. 2021, 1309, 711–717. [Google Scholar] [CrossRef]
- Cheong, K.K.; Strub, C.; Montet, D.; Durand, N.; Alter, P.; Meile, J.C.; Schorr Galindo, S.; Fontana, A. Effect of different light wavelengths on the growth and ochratoxin A production in Aspergillus carbonarius and Aspergillus westerdijkiae. Fungal Biol. 2016, 120, 745–751. [Google Scholar] [CrossRef]
- Pola-Sanchez, E.; Villalobos-Escobedo, J.M.; Carreras-Villasenor, N.; Martinez-Hernandez, P.; Beltran-Hernandez, E.B.; Esquivel-Naranjo, E.U.; Herrera-Estrella, A. A Global Analysis of Photoreceptor-Mediated Transcriptional Changes Reveals the Intricate Relationship Between Central Metabolism and DNA Repair in the Filamentous Fungus Trichoderma atroviride. Front. Microbiol. 2021, 12, 724676. [Google Scholar] [CrossRef]
- Wang, Y.; Zheng, Y.; Zhou, A.Y.; Neng, J.; Wu, D.; Shen, X.L.; Lou, X.Y.; Yang, K. Transcriptomic analysis reveals the inhibition mechanism of pulsed light on fungal growth and ochratoxin A biosynthesis in Aspergillus carbonarius. Food Res. Int. 2023, 165, 112501. [Google Scholar] [CrossRef]
- Burt, P.; Grabe, S.; Madeti, C.; Upadhyay, A.; Merrow, M.; Roenneberg, T.; Herzel, H.; Schmal, C. Principles underlying the complex dynamics of temperature entrainment by a circadian clock. Iscience 2021, 24, 103370. [Google Scholar] [CrossRef]
- Gooch, V.D.; Johnson, A.E.; Bourne, B.J.; Nix, B.T.; Maas, J.A.; Fox, J.A.; Loros, J.J.; Larrondo, L.F.; Dunlap, J.C. A Kinetic Study of the Effects of Light on Circadian Rhythmicity of the frq Promoter of Neurospora crassa. J. Biol. Rhythm. 2014, 29, 38–48. [Google Scholar] [CrossRef] [PubMed]
- Proietto, M.; Bianchi, M.M.; Ballario, P.; Brenna, A. Epigenetic and Posttranslational Modifications in Light Signal Transduction and the Circadian Clock in Neurospora crassa. Int. J. Mol. Sci. 2015, 16, 15347–15383. [Google Scholar] [CrossRef] [PubMed]
- Cockrell, A.L.; Pirlo, R.K.; Babson, D.M.; Cusick, K.D.; Soto, C.M.; Petersen, E.R.; Davis, M.J.; Hong, C.I.; Lee, K.; Fitzgerald, L.A.; et al. Suppressing the Neurospora crassa circadian clock while maintaining light responsiveness in continuous stirred tank reactors. Sci. Rep. 2015, 5, 10691. [Google Scholar] [CrossRef]
- Malzahn, E.; Ciprianidis, S.; Kaldi, K.; Schafmeier, T.; Brunner, M. Photoadaptation in Neurospora by Competitive Interaction of Activating and Inhibitory LOV Domains. Cell 2010, 142, 762–772. [Google Scholar] [CrossRef]
- Rodriguez-Pires, S.; Espeso, E.A.; Rasiukeviciute, N.; Melgarejo, P.; De Cal, A. Light-Photoreceptors and Proteins Related to Monilinia laxa Photoresponses. J. Fungi 2021, 7, 32. [Google Scholar] [CrossRef] [PubMed]
- Verde-Yanez, L.; Vall-llaura, N.; Usall, J.; Teixido, N.; Torres, R. Phenotypic plasticity of Monilinia spp. in response to light wavelengths: From in vitro development to virulence on nectarines. Int. J. Food Microbiol. 2022, 373, 109700. [Google Scholar] [CrossRef] [PubMed]
- Rodriguez-Pires, S.; Garcia-Companys, M.; Espeso, E.A.; Melgarejo, P.; de Cal, A. Influence of light on the Monilinia laxa-stone fruit interaction. Plant Pathol. 2021, 70, 326–335. [Google Scholar] [CrossRef]
- Tan, Y.; Dragovic, Z.; Roenneberg, T.; Merrow, M. Entrainment dissociates transcription and translation of a circadian clock gene in Neurospora. Curr. Biol. 2004, 14, 433–438. [Google Scholar] [CrossRef]
- Remi, J.; Merrow, M.; Roenneberg, T. A Circadian Surface of Entrainment: Varying T, tau, and Photoperiod in Neurospora crassa. J. Biol. Rhythm. 2010, 25, 318–328. [Google Scholar] [CrossRef]
- Diegmann, J.; Stuck, A.; Madeti, C.; Roenneberg, T. Entrainment elicits period aftereffects in Neurospora crassa. Chronobiol. Int. 2010, 27, 1335–1347. [Google Scholar] [CrossRef]
- Yu, S.M.; Ramkumar, G.; Lee, Y.H. Light quality influences the virulence and physiological responses of Colletotrichum acutatum causing anthracnose in pepper plants. J. Appl. Microbiol. 2013, 115, 509–516. [Google Scholar] [CrossRef]
- Costa, T.P.C.; Rodrigues, E.M.; Dias, L.P.; Pupin, B.; Ferreira, P.C.; Rangel, D.E.N. Different wavelengths of visible light influence the conidial production and tolerance to ultra-violet radiation of the plant pathogens Colletotrichum acutatum and Fusarium fujikuroi. Eur. J. Plant Pathol. 2021, 159, 105–115. [Google Scholar] [CrossRef]
- Matic, S.; Spadaro, D.; Prelle, A.; Gullino, M.L.; Garibaldi, A. Light affects fumonisin production in strains of Fusarium fujikuroi, Fusarium proliferatum, and Fusarium verticillioides isolated from rice. Int. J. Food Microbiol. 2013, 166, 515–523. [Google Scholar] [CrossRef]
- Fanelli, F.; Geisen, R.; Schmidt-Heydt, M.; Logrieco, A.F.; Mule, G. Light regulation of mycotoxin biosynthesis: New perspectives for food safety. World Mycotoxin J. 2016, 9, 129–145. [Google Scholar] [CrossRef]
- Pardo-Medina, J.; Limon, M.C.; Avalos, J. Fusarium Photoreceptors. J. Fungi 2023, 9, 319. [Google Scholar] [CrossRef]
- Fanelli, F.; Schmidt-Heydt, M.; Haidukowski, M.; Susca, A.; Geisen, R.; Logrieco, A.; Mule, G. Influence of light on growth, conidiation and fumonisin production by Fusarium uerticillioides. Fungal Biol. 2012, 116, 241–248. [Google Scholar] [CrossRef]
- Poyedinok, N.L.; Mykhailova, O.B.; Shcherba, V.V.; Buchalo, A.S.; Negriyko, A.M. Light Regulation of Growth and Biosynthetic Activity of Ling Zhi or Reishi Medicinal Mushroom, Ganoderma lucidum (W. Curt.: Fr.) P. Karst. (Aphyllophoromycetideae), in Pure Culture. Int. J. Med. Mushrooms 2008, 10, 369–378. [Google Scholar] [CrossRef]
- Rabbani, N.; Bajwa, R.; Javaid, A. Influence of culturing conditions on growth and sporulation of Drechslera hawaiiensis, the foliar blight pathogen of Marsilea minuta L. Afr. J. Biotechnol. 2011, 10, 1863–1872. [Google Scholar]
- Rasiukeviciute, N.; Brazaityte, A.; Vastakaite-Kairiene, V.; Kupcinskiene, A.; Duchovskis, P.; Samuoliene, G.; Valiuskaite, A. The Effect of Monochromatic LED Light Wavelengths and Photoperiods on Botrytis cinerea. J. Fungi 2021, 7, 970. [Google Scholar] [CrossRef]
- Zhao, E.M.; Zhang, Y.F.; Mehl, J.; Park, H.; Lalwani, M.A.; Toettcher, J.E.; Avalos, J.L. Optogenetic regulation of engineered cellular metabolism for microbial chemical production. Nature 2018, 555, 683. [Google Scholar] [CrossRef]
- Huang, H.; Lv, W.B.; Chen, Y.; Zheng, X.F.; Hu, Y.; Wang, R.H.; Huang, M.L.; Tang, H.F. The Role of NADPH Oxidase in the Inhibition of Trichophyton rubrum by 420-nm Intense Pulsed Light. Front. Microbiol. 2018, 8, 2636. [Google Scholar] [CrossRef]
- Bernal, A.R.R.; Contigiani, E.V.; Gonzalez, H.H.L.; Alzamora, S.M.; Gomez, P.L.; Raffellini, S. Botrytis cinerea response to pulsed light: Cultivability, physiological state, ultrastructure and growth ability on strawberry fruit. Int. J. Food Microbiol. 2019, 309, 108311. [Google Scholar] [CrossRef]
- Chen, F.Y.B.; Budgett, D.M.; Sun, Y.H.; Malpas, S.; McCormick, D.; Freestone, P.S. Pulse-Width Modulation of Optogenetic Photo-Stimulation Intensity for Application to Full-Implantable Light Sources. IEEE Trans. Biomed. Circuits Syst. 2017, 11, 28–34. [Google Scholar] [CrossRef]
- Hemmerich, M.; Klein, D.A.; Meyer, J.; Walther, F. Durability of the optical plastic polycarbonate under modulated blue LED irradiation at different duty cycles. Opt. Mater. 2022, 131, 11271310. [Google Scholar] [CrossRef]
- Senol, R.; Kilic, S.; Tasdelen, K. Pulse timing control for LED plant growth unit and effects on carnation. Comput. Electron. Agric. 2016, 123, 125–134. [Google Scholar] [CrossRef]
- Cho, H.; Jeon, H.J.; Park, S.; Park, C.S.; Chung, E. Neurite growth of trigeminal ganglion neurons in vitro with near-infrared light irradiation. J. Photochem. Photobiol. B-Biol. 2020, 210, 111959. [Google Scholar] [CrossRef]
- Zein, R.; Selting, W.; Hamblin, M.R. Review of light parameters and photobiomodulation efficacy: Dive into complexity. J. Biomed. Opt. 2018, 23, 120901. [Google Scholar] [CrossRef]
- Salehpour, F.; Mahmoudi, J.; Kamari, F.; Sadigh-Eteghad, S.; Rasta, S.H.; Hamblin, M.R. Brain Photobiomodulation Therapy: A Narrative Review. Mol. Neurobiol. 2018, 55, 6601–6636. [Google Scholar] [CrossRef] [PubMed]
- Tisch, D.; Schmoll, M. Light regulation of metabolic pathways in fungi. Appl. Microbiol. Biotechnol. 2010, 85, 1259–1277. [Google Scholar] [CrossRef] [PubMed]
- Suzuki, T. Light-Irradiation Wavelength and Intensity Changes Influence Aflatoxin Synthesis in Fungi. Toxins 2018, 10, 12. [Google Scholar] [CrossRef] [PubMed]
- Kitagaki, H.; Kitamoto, K. Breeding Research on Sake Yeasts in Japan: History, Recent Technological Advances, and Future Perspectives. Annu. Rev. Food Sci. Technol. 2013, 4, 215–235. [Google Scholar] [CrossRef] [PubMed]
- Gou, M.; Wang, H.Z.; Yuan, H.W.; Zhang, W.X.; Tang, Y.Q.; Kida, K. Characterization of the microbial community in three types of fermentation starters used for Chinese liquor production. J. Inst. Brew. 2015, 121, 620–627. [Google Scholar] [CrossRef]
- Du, H.; Wang, X.S.; Zhang, Y.H.; Xu, Y. Exploring the impacts of raw materials and environments on the microbiota in Chinese Daqu starter. Int. J. Food Microbiol. 2019, 297, 32–40. [Google Scholar] [CrossRef]
- Peng, M.Y.; Liu, J.Y.; Huang, Y.; Zhou, M.Z.; Hu, Y.; Fu, C.X.; Dai, J.; Wang, C.; Li, D.S.; Gao, B.; et al. Effects of a mixed koji culture of Aspergillus oryzae HG-26 and Aspergillus niger HG-35 on the levels of enzymes, antioxidants and phenolic compounds in soy sauce during the fermentation process. Int. J. Food Sci. Technol. 2017, 52, 1585–1593. [Google Scholar] [CrossRef]
- Tang, J.; Chen, T.T.; Hu, Q.; Lei, D.; Sun, Q.; Zhang, S.M.; Zeng, C.Y.; Zhang, Q. Improved protease activity of Pixian broad bean paste with cocultivation of Aspergillus oryzae QM-6 and Aspergillus niger QH-3. Electron. J. Biotechnol. 2020, 44, 33–40. [Google Scholar] [CrossRef]
- Chen, Z.Y.; Feng, Y.Z.; Cui, C.; Zhao, H.F.; Zhao, M.M. Effects of koji-making with mixed strains on physicochemical and sensory properties of Chinese-type soy sauce. J. Sci. Food Agric. 2015, 95, 2145–2154. [Google Scholar] [CrossRef]
- Leng, X.W.; Xu, Y. Improvement of acid protease production by a mixed culture of Aspergillus niger and Aspergillus oryzae using solid-state fermentation technique. Afr. J. Biotechnol. 2011, 10, 6824–6829. [Google Scholar]
- Zhu, J.-C.; Wang, X.-J. Effect of blue light on conidiation development and glucoamylase enhancement in Aspergillus niger. Weishengwu Xuebao 2005, 45, 275–278. [Google Scholar]
- Fanelli, F.; Schmidt-Heydt, M.; Haidukowski, M.; Geisen, R.; Logrieco, A.; Mule, G. Influence of light on growth, conidiation and the mutual regulation of fumonisin B-2 and ochratoxin A biosynthesis by Aspergillus niger. World Mycotoxin J. 2012, 5, 169–176. [Google Scholar] [CrossRef]

| Light Treatment | PBL | CBL | ||||||||
|---|---|---|---|---|---|---|---|---|---|---|
| Light wavelength (nm) | 475 | |||||||||
| Average light intensity (μmol·m−2·s−1) | 80 | |||||||||
| Peak light intensity (μmol·m−2·s−1) | 100 | 200 | 400 | 80 | ||||||
| Duty ratio (%) | 80 | 40 | 20 | \ | ||||||
| Frequency (Hz) | 1 | 100 | 10,000 | 1 | 100 | 10,000 | 1 | 100 | 10,000 | \ |
| Total photoperiod per 24 h | 19.2 | 9.6 | 4.8 | 24 | ||||||
| Light Treatment | PBL | CBL | ||||
|---|---|---|---|---|---|---|
| Light wavelength (nm) | 475 | |||||
| Average light intensity (μmol·m−2·s−1) | 20 | |||||
| Peak light intensity (μmol·m−2·s−1) | 40 | 80 | 100 | 200 | 400 | 20 |
| Duty ratio (%) | 50 | 25 | 20 | 10 | 5 | \ |
| Frequency (Hz) | 100 | \ | ||||
| Total photoperiod per 24 h | 12 | 6 | 4.8 | 2.4 | 1.2 | 24 |
Disclaimer/Publisher’s Note: The statements, opinions and data contained in all publications are solely those of the individual author(s) and contributor(s) and not of MDPI and/or the editor(s). MDPI and/or the editor(s) disclaim responsibility for any injury to people or property resulting from any ideas, methods, instructions or products referred to in the content. |
© 2023 by the authors. Licensee MDPI, Basel, Switzerland. This article is an open access article distributed under the terms and conditions of the Creative Commons Attribution (CC BY) license (https://creativecommons.org/licenses/by/4.0/).
Share and Cite
Lin, S.; Jiang, H.; Fu, Q.; Huang, S.; Tang, L.; Li, A.; Liu, M. Effects of Pulsed Light on Mycelium Growth and Conidiation in Aspergillus oryzae. Fermentation 2023, 9, 674. https://doi.org/10.3390/fermentation9070674
Lin S, Jiang H, Fu Q, Huang S, Tang L, Li A, Liu M. Effects of Pulsed Light on Mycelium Growth and Conidiation in Aspergillus oryzae. Fermentation. 2023; 9(7):674. https://doi.org/10.3390/fermentation9070674
Chicago/Turabian StyleLin, Shangfei, Hui Jiang, Qiqi Fu, Shijie Huang, Luyao Tang, Angze Li, and Muqing Liu. 2023. "Effects of Pulsed Light on Mycelium Growth and Conidiation in Aspergillus oryzae" Fermentation 9, no. 7: 674. https://doi.org/10.3390/fermentation9070674
APA StyleLin, S., Jiang, H., Fu, Q., Huang, S., Tang, L., Li, A., & Liu, M. (2023). Effects of Pulsed Light on Mycelium Growth and Conidiation in Aspergillus oryzae. Fermentation, 9(7), 674. https://doi.org/10.3390/fermentation9070674

